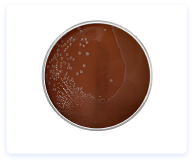
Agar chocolate
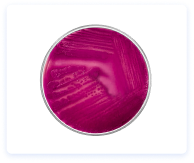
Agar MacConkey
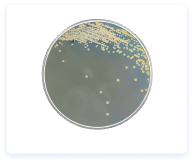
Agar Mueller Hinton
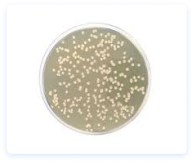
Agar nutritivo
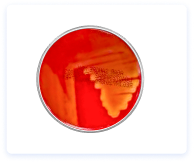
Agar sangre

Catálogo de insumos
Los insumos pueden solicitarse según disponibilidad y requerimiento operativo, con atención oportuna para pedidos prioritarios.
Toma de Muestra
Tubos y Recoleccion
Microbiología
Gasometría
Inyectables